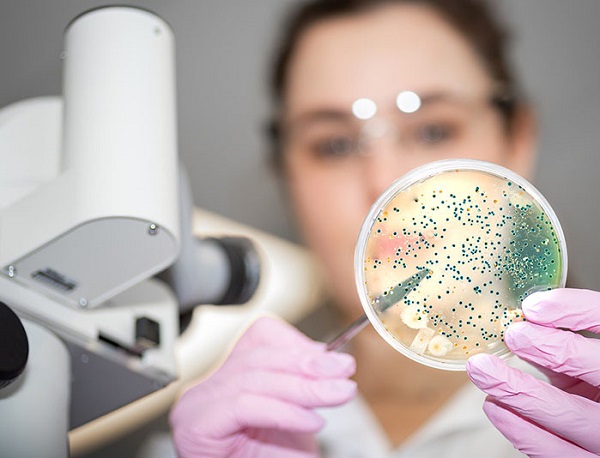

Bệnh Lậu Chữa Như Thế Nào: Hướng Dẫn Chi Tiết Và Địa Chỉ Uy Tín Tại Hà Nội
Bệnh lậu là một trong những bệnh truyền nhiễm qua đường tình dục có tỷ lệ mắc cao trên toàn cầu, ảnh hưởng đến cả nam và nữ ở nhiều độ tuổi khác nhau. Tác nhân gây bệnh là vi khuẩn Neisseria gonorrhoeae, có khả năng xâm nhập vào niêm mạc cơ quan sinh dục, hậu môn, miệng hoặc mắt. Nếu không được phát hiện và điều trị kịp thời, bệnh có thể dẫn đến viêm nhiễm nặng, vô sinh hoặc lây lan cho bạn tình.
Không ít người băn khoăn “làm sao để chữa khỏi bệnh lậu”, bởi các triệu chứng thường khởi phát âm thầm, đặc biệt ở nữ giới nên dễ bị bỏ qua. Việc thăm khám sớm, tuân thủ phác đồ điều trị của bác sĩ và tránh tự ý dùng thuốc là yếu tố then chốt giúp phục hồi nhanh và ngăn biến chứng.
Trong bài viết này, chúng tôi sẽ chia sẻ kiến thức toàn diện về bệnh lậu — bao gồm nguyên nhân, dấu hiệu nhận biết, quy trình chẩn đoán và các phương pháp điều trị được khuyến nghị theo tài liệu y khoa uy tín từ CDC Hoa Kỳ, WHO và các hướng dẫn của Bộ Y tế Việt Nam. Bên cạnh đó, bạn cũng sẽ được gợi ý một cơ sở y tế đáng tin cậy tại Hà Nội, nơi nhiều bệnh nhân đã lựa chọn để thăm khám và điều trị hiệu quả.
Bệnh lậu là gì ? Hiểu đúng để phòng và chữa kịp thời
Bệnh lậu (tên tiếng Anh: Gonorrhea) là một trong những bệnh lý lây truyền qua đường tình dục phổ biến do vi khuẩn Neisseria gonorrhoeae – thường được gọi là lậu cầu khuẩn – gây ra. Loại vi khuẩn này ưa sống ở những vị trí ẩm ướt trên cơ thể như niệu đạo, cổ tử cung, trực tràng, họng hoặc mắt, nơi chúng có thể dễ dàng sinh sôi và gây viêm nhiễm.
Đường lây truyền chủ yếu của bệnh là quan hệ tình dục không an toàn, bao gồm quan hệ qua đường âm đạo, hậu môn hay đường miệng. Ngoài ra, phụ nữ mang thai mắc bệnh lậu có thể truyền vi khuẩn sang con trong lúc sinh nở, khiến trẻ bị viêm kết mạc hoặc nhiễm trùng mắt ngay sau khi chào đời.
Theo ước tính của Tổ chức Y tế Thế giới (WHO) và Trung tâm Kiểm soát và Phòng ngừa Dịch bệnh Hoa Kỳ (CDC), mỗi năm trên thế giới có hàng chục triệu người nhiễm mới. Riêng tại Việt Nam, bệnh lậu vẫn là một trong những mối lo sức khỏe cộng đồng đáng chú ý, đặc biệt ở nhóm thanh niên có đời sống tình dục phức tạp. Bệnh xảy ra ở cả hai giới, tuy nhiên nam giới thường nhận biết sớm hơn nhờ các biểu hiện rõ ràng, còn phụ nữ lại dễ bị nhiễm âm thầm, dẫn đến nguy cơ biến chứng và lây nhiễm cho bạn tình mà không hay biết.

[Tôi chưa có thời gian đi khám, cần tư vấn online]
Nguyên nhân gây bệnh lậu – Những con đường lây truyền thường gặp
Bệnh lậu hình thành khi cơ thể bị xâm nhập bởi vi khuẩn Neisseria gonorrhoeae, hay còn gọi là lậu cầu khuẩn – một loại vi khuẩn gram âm có hình dạng song cầu, thường ký sinh ở những vùng niêm mạc ẩm ướt. Loại vi khuẩn này rất dễ lây lan nếu không có biện pháp bảo vệ khi tiếp xúc thân mật.
1. Quan hệ tình dục không an toàn – Nguyên nhân phổ biến nhất
Phần lớn các ca mắc bệnh lậu đều xuất phát từ việc quan hệ tình dục mà không dùng bao cao su. Vi khuẩn có thể lây qua bất kỳ hình thức quan hệ nào: âm đạo, hậu môn hoặc đường miệng. Các nghiên cứu y học cho thấy, nguy cơ lây bệnh từ nam sang nữ cao gấp đôi so với chiều ngược lại, do cấu trúc sinh lý của cơ quan sinh dục nữ dễ tạo điều kiện cho vi khuẩn xâm nhập.
2. Lây truyền từ mẹ sang con khi sinh nở
Phụ nữ mang thai mắc bệnh lậu có thể truyền vi khuẩn cho trẻ sơ sinh trong quá trình sinh thường. Trẻ bị lây nhiễm thường gặp biến chứng như viêm kết mạc hoặc nhiễm trùng mắt nặng, có thể dẫn đến mù lòa nếu không được xử lý kịp thời.
3. Tiếp xúc gián tiếp – Trường hợp ít gặp nhưng vẫn có thể xảy ra
Mặc dù vi khuẩn lậu không thể sống lâu ngoài môi trường, song vẫn có khả năng lây qua vật dụng cá nhân dính dịch tiết của người bệnh, chẳng hạn khăn tắm, quần lót hoặc bàn chải đánh răng. Tuy nhiên, tỷ lệ này rất thấp so với đường lây qua quan hệ tình dục.
4. Các yếu tố làm tăng nguy cơ nhiễm bệnh
Những người quan hệ với nhiều bạn tình, không dùng biện pháp bảo vệ, ở độ tuổi 15–24 hoặc đang mắc các bệnh lây truyền khác như HIV, chlamydia sẽ có nguy cơ nhiễm lậu cao hơn. Việc kiểm tra sức khỏe định kỳ và duy trì lối sống tình dục an toàn là cách tốt nhất để phòng tránh căn bệnh này.

[Tôi chưa có thời gian đi khám, cần tư vấn online]
Triệu chứng bệnh lậu ở nam và nữ – Dấu hiệu nhận biết sớm để tránh biến chứng
Thông thường, bệnh lậu bắt đầu biểu hiện sau khi nhiễm từ 2–5 ngày, nhưng ở một số người, thời gian ủ bệnh có thể kéo dài đến hai tuần. Đáng chú ý, có khoảng 10–15% nam giới và tới 80% nữ giới không xuất hiện dấu hiệu rõ ràng, khiến việc phát hiện và điều trị bị trì hoãn, làm tăng nguy cơ lây lan cho bạn tình.
Dấu hiệu bệnh lậu ở nam giới
-
Cảm giác rát buốt hoặc đau khi đi tiểu, đôi khi kèm tiểu nhiều lần trong ngày.
-
Dịch mủ chảy ra ở đầu dương vật, có màu trắng đục, vàng hoặc xanh, đặc biệt rõ vào buổi sáng.
-
Sưng đau tinh hoàn hoặc vùng bìu, biểu hiện của viêm mào tinh hoàn do vi khuẩn lan sâu.
-
Đau họng hoặc khàn tiếng nếu lây qua đường miệng.
-
Trường hợp bệnh nặng có thể kèm sốt nhẹ, mệt mỏi, đau cơ do phản ứng viêm toàn thân.
Dấu hiệu bệnh lậu ở nữ giới
-
Dịch âm đạo ra nhiều hơn bình thường, có màu vàng hoặc xanh và mùi hôi khó chịu.
-
Cảm giác đau, rát khi tiểu hoặc khi quan hệ tình dục.
-
Ra máu âm đạo bất thường ngoài kỳ kinh hoặc sau giao hợp.
-
Đau vùng bụng dưới hoặc vùng chậu – dấu hiệu viêm lan rộng đến tử cung, buồng trứng.
-
Nếu nhiễm ở họng hoặc hậu môn, người bệnh có thể thấy đau họng, ngứa rát hậu môn hoặc tiết dịch mủ.
Bệnh lậu ở trẻ sơ sinh
Khi mẹ mắc bệnh lậu trong thai kỳ mà sinh thường, trẻ có thể bị nhiễm khuẩn ở mắt, gây sưng đỏ, chảy mủ. Nếu không điều trị sớm, tình trạng này có thể dẫn đến viêm kết mạc nặng và mất thị lực.
Các triệu chứng của bệnh lậu dễ bị nhầm với viêm đường tiết niệu hoặc chlamydia, vì vậy không nên tự chẩn đoán hoặc tự mua thuốc. Việc thăm khám và xét nghiệm tại cơ sở y tế chuyên khoa là cách duy nhất để xác định chính xác và điều trị hiệu quả.

Chẩn đoán và điều trị bệnh lậu
[Tôi chưa có thời gian đi khám, cần tư vấn online]
Cách chẩn đoán bệnh lậu – Quy trình xác định chính xác và an toàn
Để xác định chính xác một người có mắc bệnh lậu hay không, việc thăm khám và thực hiện các xét nghiệm chuyên sâu là điều bắt buộc. Bởi các triệu chứng của bệnh có thể dễ nhầm lẫn với viêm nhiễm khác, nên chẩn đoán chỉ dựa vào biểu hiện lâm sàng là không đủ.
1. Xét nghiệm dịch tiết tại vùng nghi nhiễm
Bác sĩ sẽ lấy mẫu dịch từ niệu đạo (ở nam) hoặc cổ tử cung (ở nữ), đôi khi từ họng hoặc hậu môn nếu nghi ngờ lây qua các đường khác. Mẫu bệnh phẩm được nhuộm Gram để quan sát sự xuất hiện của lậu cầu khuẩn hình song cầu – dấu hiệu đặc trưng của bệnh.
2. Nuôi cấy vi khuẩn để xác định kháng thuốc
Phương pháp nuôi cấy cho phép nhận diện chính xác chủng vi khuẩn Neisseria gonorrhoeae và kiểm tra mức độ kháng kháng sinh. Đây là bước quan trọng giúp bác sĩ lựa chọn phác đồ điều trị phù hợp, đặc biệt trong bối cảnh vi khuẩn lậu ngày càng kháng thuốc mạnh.
3. Xét nghiệm khuếch đại axit nucleic (NAAT) – Phương pháp hiện đại nhất
NAAT được đánh giá là kỹ thuật chẩn đoán tiên tiến và có độ chính xác cao nhất hiện nay (95–99%). Phương pháp này có thể phát hiện vật chất di truyền của vi khuẩn trong nước tiểu hoặc dịch tiết, giúp phát hiện bệnh ngay cả ở giai đoạn sớm, khi chưa có triệu chứng rõ ràng.
4. Xét nghiệm máu hỗ trợ
Ngoài xét nghiệm đặc hiệu, bác sĩ có thể chỉ định kiểm tra máu để tầm soát các bệnh lây truyền khác như HIV, giang mai hoặc chlamydia – vốn thường xuất hiện đồng thời với bệnh lậu.
Tại các cơ sở y tế chuyên khoa uy tín, quá trình chẩn đoán luôn được tiến hành nhanh gọn, bảo mật thông tin tuyệt đối và đảm bảo sự riêng tư cho người bệnh, giúp người bệnh an tâm khi thăm khám và điều trị.
[Tôi chưa có thời gian đi khám, cần tư vấn online]
Bệnh lậu chữa như thế nào? – Giải pháp điều trị hiệu quả và an toàn hiện nay
Câu hỏi “bệnh lậu chữa như thế nào?” là thắc mắc chung của nhiều người khi phát hiện bản thân hoặc bạn tình có dấu hiệu nghi ngờ mắc bệnh. Tin vui là bệnh lậu hoàn toàn có thể điều trị khỏi nếu được phát hiện sớm, chẩn đoán chính xác và tuân thủ đúng phác đồ của bác sĩ. Tuy nhiên, do vi khuẩn Neisseria gonorrhoeae có khả năng kháng thuốc ngày càng mạnh, nên việc tự ý mua thuốc hoặc điều trị tại nhà là điều tuyệt đối không nên, vì có thể khiến bệnh nặng hơn hoặc tái phát khó kiểm soát.
1. Điều trị bằng kháng sinh – Phác đồ chuẩn được khuyến nghị
Hiện nay, kháng sinh vẫn là phương pháp điều trị chính cho bệnh lậu, được áp dụng theo hướng dẫn của CDC Hoa Kỳ và Bộ Y tế Việt Nam.
Phác đồ phổ biến nhất dành cho bệnh lậu chưa biến chứng bao gồm:
-
Ceftriaxone 500mg tiêm bắp liều duy nhất (liều lượng này đã được cập nhật trong khuyến cáo mới nhất của CDC).
-
Kết hợp với Azithromycin 1g uống liều duy nhất hoặc Doxycycline 100mg uống 2 lần/ngày trong 7 ngày nếu nghi ngờ nhiễm đồng thời chlamydia.
Đối với các trường hợp lậu kháng thuốc, bác sĩ có thể thay thế bằng:
-
Gentamicin 240mg tiêm bắp + Azithromycin 2g uống, hoặc
-
Cefixime 800mg uống nếu không thể tiêm.
Phụ nữ mang thai sẽ được chỉ định Ceftriaxone kết hợp Azithromycin (tránh Doxycycline vì ảnh hưởng đến thai nhi).
Với trẻ sơ sinh, bác sĩ sẽ sử dụng thuốc nhỏ hoặc mỡ kháng sinh cho mắt (như Erythromycin) để ngăn nhiễm trùng.
Thời gian điều trị thường kéo dài 7–14 ngày. Trong thời gian này, người bệnh cần kiêng quan hệ tình dục ít nhất 7 ngày sau khi hoàn tất liệu trình và nên tái khám sau 1–2 tuần để đảm bảo vi khuẩn đã được loại bỏ hoàn toàn.
2. Điều trị tại cơ sở y tế chuyên khoa
Với các trường hợp bệnh tiến triển nặng (như viêm mào tinh hoàn, viêm vùng chậu, nhiễm trùng lan tỏa), người bệnh có thể được nhập viện để truyền kháng sinh tĩnh mạch — thường là Ceftriaxone 1g/ngày kết hợp theo dõi chặt chẽ.
Tại Việt Nam, các bệnh viện lớn và phòng khám chuyên khoa bệnh xã hội là lựa chọn an toàn, đảm bảo bí mật thông tin và tuân thủ đúng phác đồ y tế.
3. Có nên tự chữa bệnh lậu tại nhà?
Hiện không có bất kỳ phương pháp tự chữa bệnh lậu tại nhà nào được chứng minh là hiệu quả. Những cách dân gian như dùng tỏi, lá trà xanh hay nước muối chỉ có thể làm dịu tạm thời triệu chứng, chứ không tiêu diệt được vi khuẩn lậu cầu.
Ngược lại, việc trì hoãn điều trị có thể khiến bệnh lan rộng, gây vô sinh hoặc viêm nhiễm mạn tính. Người bệnh cần đến cơ sở y tế uy tín để được xét nghiệm và điều trị đúng cách ngay khi có dấu hiệu nghi ngờ.
4. Phương pháp hiện đại hỗ trợ điều trị
Hiện nay, nhiều cơ sở y tế đã ứng dụng kỹ thuật DHA (Dynamic High-frequency Treatment) – một công nghệ điều trị tiên tiến kết hợp sóng điện từ và thuốc kháng sinh.
Phương pháp này giúp tăng khả năng thẩm thấu của thuốc, tiêu diệt vi khuẩn nhanh hơn và giảm nguy cơ tái phát, đặc biệt hiệu quả với bệnh lậu mãn tính hoặc lậu kháng thuốc.
5. Lưu ý trong quá trình điều trị
-
Bạn tình cần được điều trị song song để tránh lây nhiễm chéo.
-
Không tự ý ngừng thuốc dù triệu chứng đã giảm.
-
Tái khám định kỳ để kiểm tra kháng thuốc.
-
Quan hệ tình dục an toàn và giữ vệ sinh cá nhân để phòng ngừa tái phát.
Nếu bạn đang tìm kiếm địa chỉ điều trị bệnh lậu an toàn, kín đáo và hiệu quả tại Hà Nội, có thể tham khảo Phòng khám Đa khoa Quốc tế Cộng Đồng, nơi áp dụng công nghệ DHA kết hợp phác đồ kháng sinh chuẩn y khoa, giúp nhiều bệnh nhân phục hồi nhanh và ngăn tái phát.

[Tôi chưa có thời gian đi khám, cần tư vấn online]
Biến chứng nguy hiểm khi không điều trị bệnh lậu kịp thời
Bệnh lậu nếu không được phát hiện và điều trị sớm không chỉ gây khó chịu trong sinh hoạt mà còn ảnh hưởng nghiêm trọng đến sức khỏe sinh sản và toàn thân. Vi khuẩn Neisseria gonorrhoeae có khả năng lan nhanh từ cơ quan sinh dục đến các cơ quan khác, để lại nhiều hậu quả khó lường.
1. Ở nam giới
Khi vi khuẩn lậu không được kiểm soát, chúng có thể lan đến mào tinh hoàn, gây viêm đau, sưng tấy và tăng nguy cơ tắc ống dẫn tinh. Nếu không can thiệp sớm, tình trạng này dễ dẫn đến vô sinh do giảm số lượng và chất lượng tinh trùng. Ngoài ra, sẹo hẹp niệu đạo cũng là biến chứng phổ biến, khiến việc đi tiểu trở nên đau rát và khó khăn.
2. Ở nữ giới
Phụ nữ mắc bệnh lậu mà không điều trị có thể bị viêm vùng chậu (PID) – một biến chứng nghiêm trọng ảnh hưởng đến tử cung, buồng trứng và ống dẫn trứng. Điều này làm tăng nguy cơ vô sinh, mang thai ngoài tử cung, hoặc sảy thai liên tiếp. Ngoài ra, bệnh lậu cũng khiến nguy cơ nhiễm HIV cao hơn do tổn thương niêm mạc sinh dục tạo điều kiện cho virus xâm nhập.
3. Biến chứng toàn thân
Trong những trường hợp vi khuẩn lậu xâm nhập vào máu, người bệnh có thể bị nhiễm trùng lan tỏa (DGI) – gây viêm khớp, viêm màng tim, viêm gan hoặc nhiễm trùng huyết. Đây là biến chứng nặng, có thể đe dọa tính mạng nếu không được điều trị kịp thời.
4. Ở trẻ sơ sinh
Khi người mẹ bị lậu nhưng không được điều trị trước khi sinh, trẻ có thể bị lây nhiễm qua đường sinh thường, dẫn đến viêm kết mạc mủ ở mắt, khiến mắt sưng đỏ, chảy mủ nhiều và có thể mù lòa vĩnh viễn nếu không can thiệp sớm.
Tóm lại, bệnh lậu không chỉ ảnh hưởng đến sức khỏe sinh sản mà còn tiềm ẩn nhiều rủi ro cho toàn cơ thể. Phát hiện sớm – điều trị đúng phác đồ – tái khám định kỳ là chìa khóa để phòng ngừa biến chứng và bảo vệ sức khỏe lâu dài.
Cách phòng ngừa bệnh lậu – Chủ động bảo vệ sức khỏe tình dục an toàn
Phòng tránh bệnh lậu không chỉ dựa vào điều trị mà quan trọng hơn là duy trì lối sống tình dục lành mạnh và ý thức tự bảo vệ bản thân. Dưới đây là những biện pháp giúp giảm thiểu nguy cơ lây nhiễm hiệu quả nhất:
1. Quan hệ tình dục an toàn
Sử dụng bao cao su đúng cách trong mọi hình thức quan hệ — dù là qua đường âm đạo, hậu môn hay miệng — là biện pháp đơn giản nhưng cực kỳ hiệu quả trong việc ngăn vi khuẩn lậu lây lan. Hãy chắc chắn rằng bao cao su được sử dụng từ đầu đến cuối quá trình quan hệ.
2. Kiểm tra sức khỏe định kỳ
Nếu bạn đang trong mối quan hệ mở hoặc có nhiều bạn tình, nên thực hiện xét nghiệm các bệnh lây qua đường tình dục định kỳ (ít nhất 6 tháng/lần). Việc phát hiện sớm giúp điều trị kịp thời và tránh lây nhiễm cho người khác.
3. Tuân thủ điều trị và kiêng quan hệ khi đang mắc bệnh
Trong thời gian điều trị bệnh lậu, cần ngừng hoàn toàn việc quan hệ tình dục để tránh lây nhiễm chéo hoặc tái nhiễm. Bạn tình cũng cần được kiểm tra và điều trị song song.
4. Tiêm vắc-xin hỗ trợ phòng bệnh lây truyền khác
Hiện tại, chưa có vắc-xin đặc hiệu phòng ngừa bệnh lậu, tuy nhiên, tiêm phòng HPV hoặc viêm gan B vẫn giúp giảm nguy cơ mắc các bệnh lây truyền khác, góp phần bảo vệ sức khỏe sinh sản toàn diện.
5. Nâng cao nhận thức và giáo dục giới tính
Việc trang bị kiến thức đúng về quan hệ tình dục an toàn cho thanh thiếu niên và cộng đồng là biện pháp bền vững nhất để hạn chế bệnh lây lan. Mỗi người cần hiểu rõ về hậu quả của việc quan hệ không an toàn và tầm quan trọng của việc kiểm tra sức khỏe định kỳ.
Tóm lại: Phòng bệnh lậu không khó nếu bạn chủ động bảo vệ bản thân, chung thủy trong quan hệ, và thường xuyên kiểm tra sức khỏe. Một chút cẩn trọng hôm nay có thể giúp bạn tránh được nhiều hệ lụy nghiêm trọng trong tương lai.

[Tôi chưa có thời gian đi khám, cần tư vấn online]
Địa chỉ chữa bệnh lậu uy tín tại Hà Nội – Phòng Khám Đa Khoa Quốc Tế Cộng Đồng
Nếu bạn đang lo lắng vì nghi ngờ mắc bệnh lậu và chưa biết nên khám ở đâu an toàn, hiệu quả, thì Phòng Khám Đa Khoa Quốc Tế Cộng Đồng (địa chỉ: 193C1 Bà Triệu, Quận Hai Bà Trưng, Hà Nội) là một trong những lựa chọn đáng tin cậy hàng đầu hiện nay.
Phòng khám được Sở Y tế Hà Nội cấp phép hoạt động, chuyên sâu trong thăm khám và điều trị các bệnh xã hội như lậu, giang mai, sùi mào gà, viêm niệu đạo, viêm âm đạo do vi khuẩn…
Vì sao nhiều bệnh nhân tin tưởng lựa chọn Phòng Khám Đa Khoa Quốc Tế Cộng Đồng?
1. Đội ngũ bác sĩ chuyên khoa giàu kinh nghiệm
Phòng khám quy tụ các bác sĩ đầu ngành về bệnh xã hội và da liễu, từng công tác tại các bệnh viện lớn ở Hà Nội. Mỗi phác đồ điều trị đều được cá nhân hóa theo tình trạng bệnh, tuân thủ hướng dẫn chuyên môn của Bộ Y tế và CDC Hoa Kỳ, giúp nâng cao hiệu quả điều trị và hạn chế tối đa tái phát.
2. Ứng dụng công nghệ điều trị hiện đại
Hiện phòng khám đang triển khai kỹ thuật DHA cải tiến, kết hợp kháng sinh liều cao chọn lọc, có khả năng tiêu diệt vi khuẩn nhanh, phục hồi mô tổn thương và ngăn ngừa biến chứng. Phương pháp này đặc biệt phù hợp với bệnh lậu mãn tính, tái phát hoặc kháng thuốc.
3. Minh bạch chi phí – Nhiều ưu đãi hỗ trợ người bệnh
Chi phí khám và điều trị luôn được niêm yết rõ ràng theo quy định của Sở Y tế. Ngoài ra, phòng khám thường xuyên triển khai chương trình ưu đãi như:
-
Miễn phí chi phí khám ban đầu hoặc giảm 30–50% phí điều trị thủ thuật.
-
Gói hỗ trợ dành riêng cho bệnh nhân ngoại tỉnh hoặc sinh viên có hoàn cảnh khó khăn.
4. Dịch vụ y tế chuyên nghiệp – Tận tâm – Bảo mật
Phòng khám làm việc tất cả các ngày trong tuần từ 8h00 – 20h00, kể cả ngày lễ, Tết.
Người bệnh có thể đặt lịch hẹn trực tuyến hoặc tư vấn miễn phí qua hotline 0243.9656.999 để được hỗ trợ nhanh nhất.
Mọi thông tin cá nhân và hồ sơ bệnh án đều được bảo mật tuyệt đối, giúp bệnh nhân yên tâm khi thăm khám các bệnh nhạy cảm.

[Tôi chưa có thời gian đi khám, cần tư vấn online]
5. Đánh giá tích cực từ bệnh nhân thực tế
Nhiều người bệnh sau điều trị phản hồi tốt:
“Tôi điều trị lậu mãn tính tại đây chỉ trong 2 tuần, bác sĩ rất tận tình, theo dõi sát sao và chi phí rõ ràng, không phát sinh.”
Các đánh giá tích cực này xuất hiện thường xuyên trên diễn đàn sức khỏe và trang mạng xã hội, phản ánh chất lượng điều trị thực tế.
Bệnh lậu có thể chữa khỏi hoàn toàn nếu được phát hiện sớm và điều trị đúng phác đồ. Việc lựa chọn cơ sở y tế uy tín, bác sĩ chuyên môn cao là yếu tố quyết định kết quả điều trị.
Nếu bạn đang tìm kiếm nơi khám chữa an toàn – kín đáo – hiệu quả, hãy liên hệ ngay với Phòng Khám Đa Khoa Quốc Tế Cộng Đồng để được tư vấn miễn phí và đặt lịch khám nhanh nhất.



